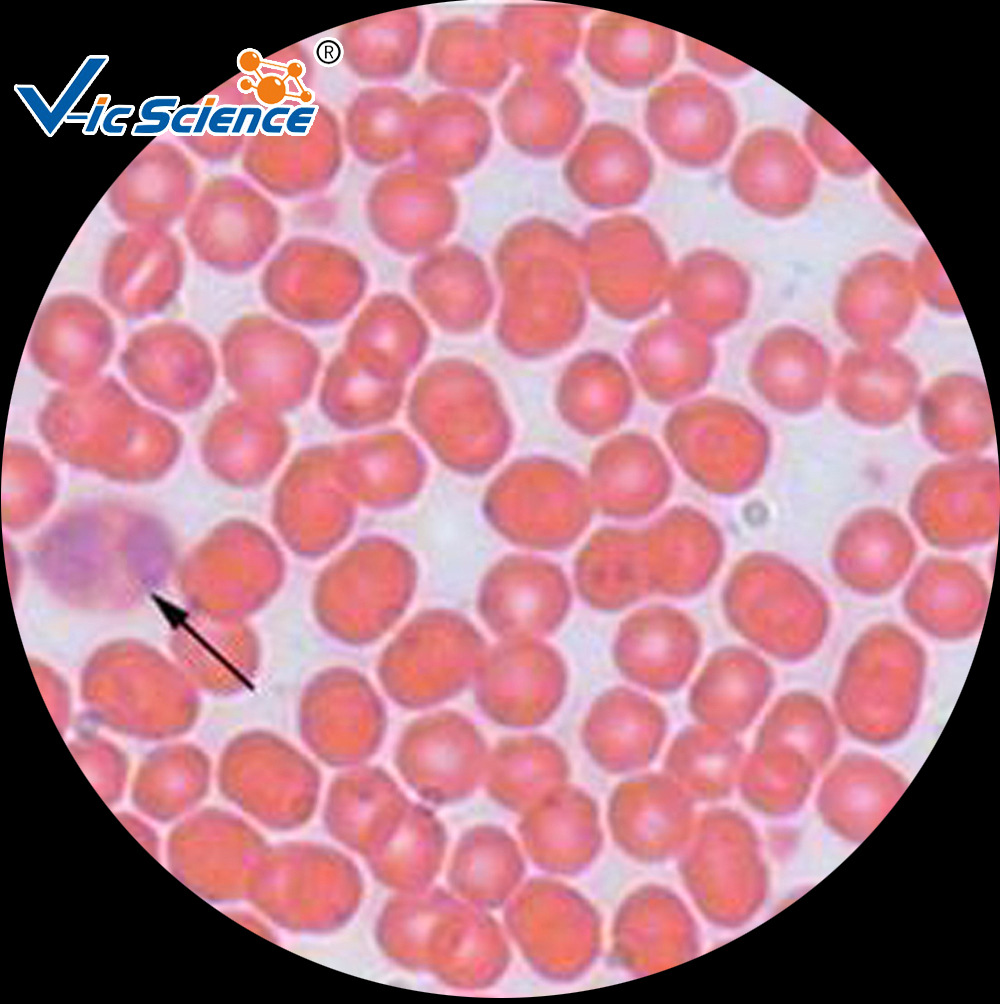
人血涂片 组织学与胚胎学 动植物切片标本 中小学显微镜玻片
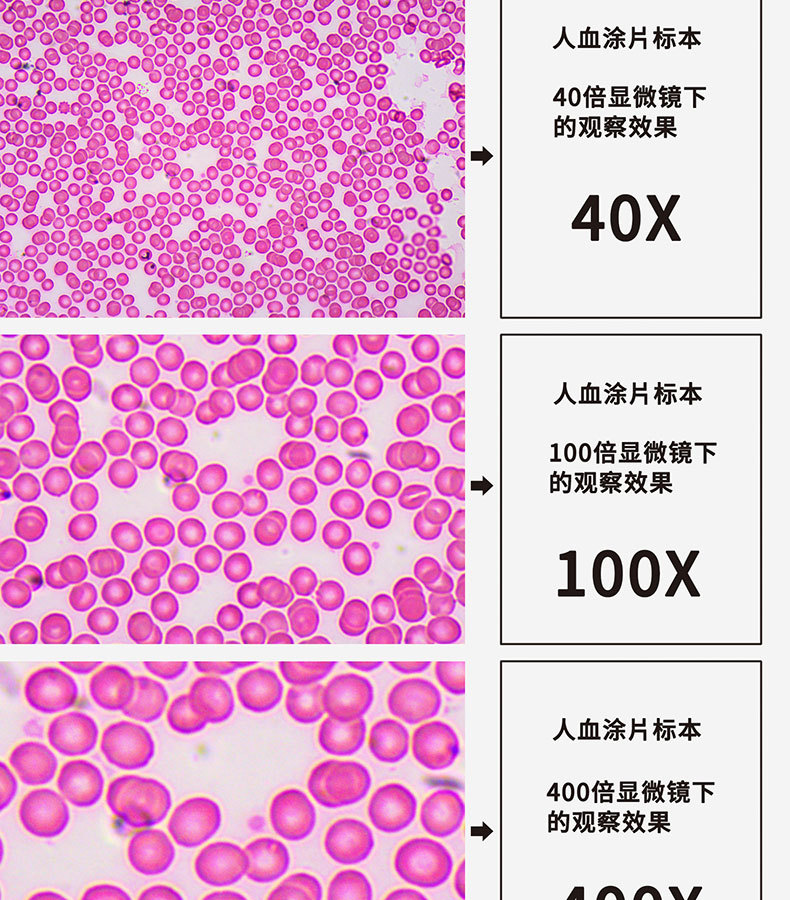
凤凰生物显微镜ph100无限远ipl光学系统高清科研医学水产养殖用

人血 显微镜
显微镜观察人血的永久涂片,10×目镜,物镜10×/20×,手机直拍图,显微
图片尺寸640x480显微镜观察人血的永久涂片,10×目镜,物镜10×/20×,手机直拍图,显微
图片尺寸640x480
显微镜94下的人血涂片
图片尺寸1920x2560显微镜,人血细胞,在下面,白血病,免疫学
图片尺寸1200x1043
显微镜下的人血细胞放大1600倍观察人血细胞
图片尺寸1440x2560
显微镜94下的人血涂片
图片尺寸1920x2560
人血涂片生物显微镜标本切片红细胞白细胞显像清晰易观察显微玻片 人
图片尺寸350x350
人血,显微镜,涂抹
图片尺寸477x350
显微镜94下的人血涂片 图一图二 低倍镜 图三图四 高倍镜 图中
图片尺寸1920x2560
显微镜下的人血细胞放大1600倍观察人血细胞
图片尺寸1440x2560
陈键宏科学显微镜实验
图片尺寸1600x1200
人血涂片 组织学与胚胎学 动植物切片标本 中小学显微镜玻片
图片尺寸1000x1004
人血装片(自己的血)
图片尺寸816x1440
人血细胞,夹竹桃茎横切,黑藻叶放大图片#科学实验#显微镜#血 - 抖音
图片尺寸1440x1920
看见不同——云经尚品中英文小学特色科学课_细胞_显微镜_class
图片尺寸1080x1208
凤凰生物显微镜ph100无限远ipl光学系统高清科研医学水产养殖用
图片尺寸790x900
用显微镜观察人血的永久涂片
图片尺寸1280x720
人类血下的显微镜血涂片人类
图片尺寸282x280
显微镜下的人血细胞放大1600倍观察人血细胞
图片尺寸1440x2560
人体血液在显微镜下观看真是太神器了!
图片尺寸583x364
猜你喜欢:显微镜下的血人血显微镜图片人血涂片显微镜人血涂片显微镜图片人血细胞显微镜图显微镜观察人血涂片显微镜人血涂片显微镜结构图血涂片显微镜下图片人血显微镜下细胞画图显微镜图片显微镜下的细菌光学显微镜显微镜人血涂片手绘图显微镜真菌鸡血涂片显微镜图片显微镜的结构图显微镜的基本结构显微镜的使用方法显微镜简笔画人血涂片人血涂片图人血涂片示意图人血涂片结构图人血涂片绘图人血涂片制作步骤人血涂片的细胞图片人血涂片结构示意图人血涂片白细胞图片人血的永久涂片示意图thejunglebengi余静萍喀喇昆仑高原在哪里ff14武士50级校服建筑景观图例丹的笔画月经完后几天容易怀孕异物巨细胞马戏团图片巫师2佳尼特电热水器A1草莓酱简笔画